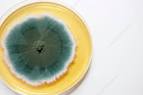
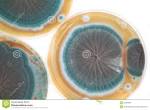

गोमफस क्लैवाटस
गोमफस क्लैवेटस , जिसे आमतौर पर सुअर के कान या वायलेट चैंटरेल के रूप में जाना जाता है, जीनस गोमफस मूल में यूरेशिया और उत्तरी अमेरिका में खाद्य फंगस की एक प्रजाति है। फलों का शरीर फूलदार किनारों वाला होता है, जिसके किनारों पर लहराती धार होती है, और 15-16 सेमी तक बढ़ती है 14 इंच चौड़ा और 17 सेमी 3 3 4इंच) लंबा। ऊपरी सतह या टोपी नारंगी -भूरे रंग की होती है, जबकि निचली बीजाणु- सतह, हाइमेनियम , गलफड़ों या छिद्रों के बजाय झुर्रियों और लकीरों में ढकी होती है, और एक विशिष्ट बैंगनी रंग होता है।
वैज्ञानिक वर्गीकरण
किंगडम: कवक, विभाजन: Basidiomycota,
वर्ग: Agaricomycetes, आर्डर: Gomphales,
परिवार: Gomphaceae, जीनस: Gomphus,
प्रजाति: गोमफस क्लैवाटस,
सामान्य विवरण
आमतौर पर शंकुधारी जंगलों में पाया जाता है , गोमफस क्लैवाटस माइकोरिज़ल है , और विभिन्न प्रकार के शंकुधारी जेनेरा में पेड़ की प्रजातियों के साथ जुड़ा हुआ है, विशेष रूप से स्प्रिंग्स और फ़िरस । यह पत्ती के कूड़े के साथ नम, छायादार क्षेत्रों में 2,000 फीट (600 मीटर) से अधिक की ऊंचाई पर अधिक आम है। हालांकि व्यापक रूप से, जी क्लैवेटस यूरोप के कई हिस्सों में दुर्लभ हो गया है और ब्रिटिश द्वीपों में विलुप्त हो गया है। यह 17 अलग-अलग यूरोपीय देशों में खतरे की कवक की राष्ट्रीय रेड लिस्ट में रखा गया है और बर्न कन्वेंशन के तहत अंतर्राष्ट्रीय संरक्षण के लिए प्रस्तावित 33 प्रजातियों में से एक है।
टैक्सोनॉमी(वर्गीकरण विज्ञान ) :
जर्मन प्रकृतिवादी जैकब क्रिस्चियन शॉफर ने 1774 में एलेवा पुरपुरस्केंस का वर्णन किया। ऑस्ट्रियाई प्रकृतिवादी फ्रांज ज़ावर वॉन वुल्फेन ने इसे 1781 में क्लावरिया एल्वेलोइड्स नाम दिया था, उन्होंने बताया कि यह अगस्त में क्लेगेनफ़र्ट के आसपास के जंगलों के जंगलों में दिखाई दिया और आम था। Hüttenberg उन्होंने दर्ज किया कि गरीब लोगों ने इसे खा लिया, इसे स्थानीय नाम हरे का नाम दिया। १ 4 ९ ६ में,
माइकोलॉजिस्ट क्रिश्चियन हेंड्रिक परसून ने गोमफस क्लैवाटस को मेरुलियस क्लैवाटस के रूप में वर्णित किया , यह देखते हुए कि यह जंगल में घास के स्थानों में बढ़ता है। उन्होंने कहा कि यह वही प्रजाति थी जिसका वर्णन शेफर ने किया था। विशिष्ट शब्द – लैटिन शब्द क्लवा (क्लब) और जिसका अर्थ है “क्लब के आकार का” – युवा फल निकायों के आकार में परिवर्तित। अपने सिनोप्सिस मेथोडिका कवक में , पारस ने मेरुलियस के भीतर गोमफस के खंड में मेरुलियस क्लैवाटस (दो किस्मों को पहचानते हुए – वायलेसस और स्पैडिसस ) रखा ।
ब्रिटिश वनस्पतिशास्त्री सैमुअल फ्रेडरिक ग्रे ने पर्सोन के नाम का इस्तेमाल किया, 1821 में वायलेट चैंटर को जीनस गोमफस में स्थानांतरित किया। जैसा कि यह जीनस का पहला नामित सदस्य था, यह टाइप प्रजाति बन गया। स्वीडिश प्रकृतिवादी एलियास मैग्नस फ्राइज़ के कार्यों की तारीख से मेल खाने के लिए फंगल टैक्सोनॉमी की प्रारंभिक तिथि 1 जनवरी, 1821 निर्धारित की गई थी, जिसका अर्थ था फ्राइज़ द्वारा अपेक्षित नाम (एक कॉलन द्वारा नाम में इंगित) वैध माना जाता है।

इस प्रकार प्रजाति को गोम्फस क्लैवेटस ग्रे के रूप में लिखा गया था। 1987 के इंटरनेशनल कोड ऑफ़ बोटैनिकल नोमेनक्लेचर के एक संशोधन ने लिनिअस द्वारा 1 मई, 1753 को प्रजाति प्लांटरम के प्रकाशन की तारीख शुरू की। इसलिए, नाम को अब फ्राइज़ के प्राधिकरण के अनुसमर्थन की आवश्यकता नहीं है।पारसून ने अपने काम मायकोलाजी यूरोपिया में एक अलग जीनस के रूप में गोमफस के इलाज में सूट का पालन किया। यहां उन्होंने एम। क्लेवेटस को उसी प्रजाति के रूप में मान्यता दी, जिसे क्लैवरिया ट्रुनाकाटा ने १ ९ ६ ९ में कासिमिर क्रिस्टोफ श्मिडेल द्वारा वर्णित किया गया था, टैक्सन गोम्फस ट्रंकैटस कहा ।

फ्राइज़ ने खुद को जीनस को अलग रखने के लिए मना कर दिया, इसके बजाय गोमफस को एक जनजातीय ( उपजाति ) के रूप में वर्गीकृत करते हुए अपने काम सिस्टेरा मायकोलॉजिकम में जीनस कैंरेहेलस के भीतर, कैंथरेस क्लैवाटस बनने वाली प्रजाति है। उन्होंने चार किस्मों को मान्यता दी: वायलेसो-स्पैडिसस , कार्नेस , पुरपुरस्केंस और ओम्ब्रिनस । स्विस माइकोलॉजिस्ट लुईसीक्रेटन ने तीन टैक्सों का वर्णन किया – मेरुलियस क्लैवाटस कार्नस , एम। क्लेवेटस वाइटेसस और एम। क्लेवेटस पुरपुरस्केन्स वर्क माइकोोग्राफी सुइस ।
उनके कई नाम नामकरण संबंधी उद्देश्यों के लिए अस्वीकार कर दिए गए हैं क्योंकि सीक्रेट में एक संकीर्ण प्रजाति की अवधारणा थी , कई टैक्सों को कई प्रजातियों में विभाजित किया गया था जो अन्य अधिकारियों द्वारा समर्थित नहीं थे, और उनके कार्यों ने लगातार द्विपद नामकरण का उपयोग नहीं किया था। फ्राइज़ ने अपनी पुस्तक एपिक्रिसिस सिस्टैटिस मायकोलॉजिक सेउसिनोप्सिस हाइमेनोमाइसेटम में अपने वर्गीकरण को संशोधित करते हुए इसे एक श्रृंखला में रखा है – विरूपस -जीनस क्रेटेरस ।

1897 अल्बिन शल्मफस द्वारा चित्रण
पॉल कुम्मर ने अपने 1871 के काम डेर फ्युहरर को डाई पिल्ज़कुंडे में जीनस थेलेफोरा में वायलेट चेंटरेल को वर्गीकृत करते हुए फ्राइज़ की कई जनजातियों ( उपस्नेका ) को जीनस रैंक तक उठाया । जैक्स एमिल डासंस और नार्सिसस थियोफाइल पटौइलार्ड ने इसे १, ,६ में जीनस न्यूरोफिलम ( नेवॉर्टलम में भी लिखा था ) में रखा, इसके ऑरेंज बीजाणुओं के कारण इसे कैंटरेलस से हटा दिया। चार्ल्स होर्टन पेक ने 1887 में नाम को त्याग दिया और जी। क्लेवेटस को कैंथ्रेलस को लौटा दिया। जर्मन वनस्पतिशास्त्री ओटो कुन्त्जे ने रेविसियो जेनम प्लांटरम को प्रकाशित किया, जो मौजूदा नामकरण पद्धति में उन्हें खराब पद्धति के रूप में माना जाता है। उन्होंने वायलेट चेंटरेल को शामिल करने के लिए जीनस ट्रॉम्बेटा को गढ़ा, इसलिए इसे ट्रोम्बेटा क्लैवाटा नाम दिया गया। हालांकि, कुंतज़े के संशोधन कार्यक्रम को अधिकांश वनस्पति विज्ञानियों ने स्वीकार नहीं किया।

अलेक्जेंडर एच। स्मिथ ने 1947 में पश्चिमी उत्तरी अमेरिका में चेंटरलेल्स की अपनी समीक्षा में कैंटरेलस के भीतर एक खंड के रूप में गोमफस का इलाज किया, क्योंकि उन्होंने महसूस किया कि कोई संगत विशेषताएं नहीं थीं जो दोनों पीढ़ी को अलग करती थीं। १ ९ ६६ में EJH कॉर्नर ने एक छोटी-प्रायोजित विविधता, जी। क्लेवेटस var का वर्णन किया। युगांडा में एकत्र किए गए नमूनों से परविस्पोरा ; इसका स्वतंत्र वर्गीकरण महत्व नहीं माना जाता है।
2000 के दशक के शुरुआती दिनों में डीएनए अनुक्रमों और अधिक पारंपरिक आकारिकी- आधारित वर्णों के फायलोजेनेटिक विश्लेषण के उपयोग के संयोजन के परिणामस्वरूप गोम्फस में प्रजातियों की अवधारणा में फेरबदल किया गया ; इसके परिणामस्वरूप, जी क्लैवेटस को उत्तरी अमेरिका में एकमात्र गोमफस प्रजाति माना जाता है।प्रजातियों के डीएनए अनुक्रमों की तुलना गोमफस ब्रेवाइप्स और गोमफस ट्रंकैटस ने उन्हें आनुवंशिक रूप से जी क्लैवाटस के समान दिखाया है, और उन्हें समानार्थक शब्द के रूप में माना जा सकता है।
गोमफस क्लैवेटस को आमतौर पर सुअर के कान के रूप में जाना जाता है, जो बैंगनी अन्डराइड और फलों के पिंडों की पीली टोपी के साथ होता है , हालांकि इस वर्नाकुलर नाम का उपयोग डिस्किना पर्लाटा के लिए भी किया जाता है। इस प्रजाति के अन्य अंग्रेजी आम नामों में क्लस्टर्ड चेंटरेल और वायलेट चेंटरेल शामिल हैं। नेपाल की शेरपा भाषा में फंगस को ईश्यामो (“सास”) के रूप में जाना जाता है, क्योंकि इसका थोपा हुआ फल शरीर एक सास की याद दिलाता है, जिसकी शेरपा परिवार में प्रमुख भूमिका है।
विवरण

हाइमेनियम की झुर्रीदार और उठी हुई सतह
अपरिपक्व गोम्फस क्लैवाटस के बेसिडियोकार्प्स या फलों के पिंड क्लब के आकार के होते हैं और इनमें एक टोपी या पाइलस होता है , लेकिन बाद में फैल जाता है और एक तथाकथित मेरिस्मैटॉइड रूप होता है – एक आम तने से उठने वाले कई फूलदान के आकार के कैप। फलों का शरीर 15 सेमी (6 इंच) चौड़ा और 17 सेमी ( 6) तक होता है लहराती किनारों के साथ 3 से 4 इंच लंबा, पंखे के आकार का। फलों के पिंडों की ऊपरी सतह भूरे हाइप (सूक्ष्म फ़िलामेंट्स ) से ढकी होती है , जो मार्जिन की ओर छोटे, अलग-अलग पैच बनाते हैं, लेकिन कैप के केंद्र के ऊपर एक निरंतर महसूस किए जाने वाले महीन बालों वाले क्षेत्र, या टूनामेंट के रूप में संयोजित होते हैं । ऊपरी टोपी की सतह का रंग नारंगी-भूरे रंग से बैंगनी है, लेकिन उम्र के साथ हल्के भूरे रंग का है। पुराने मशरूम के कैप मार्जिन को काफी कम किया जा सकता है। निचली बीजाणु-असर वाली सतह – हाइमनियम झुर्रियों वाली होती है, जो अक्सर सिलवटों और गड्ढों के साथ होती है और बैंगनी रंग की होती है। ठोस तना , जो कैप के साथ निरंतर होता है, 0.8–3 सेमी ( 3 – 8 – 1) होता है 8 इंच चौड़ा, 4–10 सेमी 5 – 8 इंच लंबा,और ठीक बालों के साथ कवर किया जाता है जो बेस की ओर मोटे (हर्पिड) बन जाते हैं।

यह अक्सर यौगिक होता है, जिसमें कई फलों के शरीर बेसल भाग से उत्पन्न होते हैं। फलों का शरीर लाल-भूरे रंग का हो सकता है जहां संभाला जाता है। मांस श्वेत-गुलाबी हो सकता है, बकाइन या दालचीनी-बफ तक। टोपी के केंद्र के नीचे मोटी, यह मार्जिन की ओर बाहर निकलती है। यह कुरकुरे हो सकता है, हालांकि यह चेंटरेल की तुलना में नरम है। स्वाद और गंध हल्के होते हैं। बीजाणु का प्रिंट पीला से नारंगी-पीला होता है।
बीजाणु अण्डाकार, झुर्रीदार या थोड़े मस्से वाले होते हैं, और 10–14 5–7.5 सुक्ष्ममापी होते हैं । वे नॉनमायलोइड हैं , जिसका अर्थ है कि वे मेल्ज़र के अभिकर्मक में आयोडीन के साथ एक नकारात्मक रंग प्रतिक्रिया करते हैं। बीजाणु-असर संरचनाएं, बेसिडिया , लम्बी या क्लब के आकार की, हाइलिन (ग्लासी या पारभासी), और चार-बीजाणु, 60-90 के आयामों के साथ 8.511.5 माइक्रोन तक होती हैं।गोमफस क्लैवाटस में सिस्टिडिया नहीं है, कई प्रजातियों में बेसिडिया से जुड़ी बाँझ कोशिकाएँ हैं। क्लैंप कनेक्शन मौजूद हैं।
आवास, और संरक्षण
गोम्फस क्लैवाटस एक परी अंगूठी में फलाना
जमीन पर बढ़ते हुए, गोमफस क्लैवेटस मशरूम गुच्छों या गुच्छों में, या कभी-कभी परी के छल्ले के रूप में भी दिखाई देते हैं । प्रजाति आमतौर पर शंकुधारी जंगलों में पाई जाती है, और जमीन पर गहरे पत्तों वाले कूड़े , या सड़े हुए लकड़ी के मलबे के साथ नम, छायादार क्षेत्रों के लिए एक प्राथमिकता है। यह पेड़ों के पुराने या छोटे स्टैंड में समान रूप से आम है। फलों के शरीर आसानी से छूट जाते हैं क्योंकि उनके रंग जंगल के फर्श से मिलते हैं। यह २००० फीट (६०० मीटर) से अधिक की ऊंचाई पर अधिक आम है।
वितरण
गोम्फस क्लैवेटस को विभिन्न प्रकार के पेड़ों के साथ सहजीवी ( माइकोराइजल ) संघों के गठन के रूप में सूचित किया गया है: एबिस अल्बा , एबिस सेफेलोनिका , एब्स फ़रमा , एबिस नेफ्रोल्पिस , एबिसधर्मियोसा , पिका प्रजाति, पीनस डेंसिफ्लोरा , स्यूडोटसुगा मेन्ज़ीसी , और त्सुगा हेटरोफिला । यह यूरोप में बीच ( फेगस सिल्वेटिक ) के साथ भी बताया गया है।
संरक्षण
एशिया में, चीन, जापान, कोरिया, मलेशिया, नेपाल, और पाकिस्तान से गोमफस क्वाटेटस की सूचना मिली है। यूरोपीय देशों में जहां कवक की सूचना मिली है, उनमें ऑस्ट्रिया, चेक गणराज्य, फ्रांस, जर्मनी, ग्रीस, इटली, लिथुआनिया,पोलैंड , रोमानिया, रूस,स्वीडन, स्विट्जरलैंड, और तुर्की। उत्तरी अमेरिका में, कवक कनाडा, मेक्सिको, और संयुक्त राज्य अमेरिका में पाया गया है, जहां यह प्रशांत उत्तरपश्चिम में प्रचुर मात्रा में है।
यूरोप में, गोमफस क्लैवेटस 17 देशों में खतरे की कवक की राष्ट्रीय लाल सूची में दिखाई देता है और बर्न कन्वेंशन के तहत अंतर्राष्ट्रीय संरक्षण के लिए प्रस्तावित कवक की 33 प्रजातियों में से एक है। दृष्टि में पर्याप्त गिरावट के कारण, १ सितंबर, २००५ को गोमफस क्लैवेटस हंगरी में कानूनी रूप से संरक्षित प्रजाति बन गया। इसे स्लोवाकिया और स्लोवेनिया में भी कानूनी संरक्षण प्राप्त है। यह प्रजाति पूर्व में ब्रिटिश द्वीपों में पाई जाती थी, लेकिन इसे नहीं देखा गया और अब इसे विलुप्त माना जाता है। कवक को अपने निवास स्थान के नुकसान और गिरावट का सामना करना पड़ता है;यूट्रोफिकेशन (मिट्टी में नाइट्रेट्स में वृद्धि) एक और संभावित खतरा है। जर्मन माइकोलॉजिकल सोसाइटी द्वारा आंशिक रूप से अपनी कमजोर स्थिति को उजागर करने के लिए पिल्ले डेस जहेरेस (“मशरूम ऑफ द ईयर”) के रूप में गोमफस क्लैवेटस को चुना गया था।

गोमफस क्लैवाटस खाद्य :
इसे कुछ लोगों द्वारा पसंद के रूप में रेट किया गया है, जबकि अन्य इसे बेस्वाद पाते हैं। इसमें एक मिट्टी का स्वाद और मांस की बनावट होती है जिसे सूटिंग रेड मीट व्यंजन माना जाता है। कई खाद्य कवक की तरह, अतिसंवेदनशील व्यक्तियों में खपत गैस्ट्रोइंटेस्टाइनल संकट का कारण हो सकता है। मांस उम्र के साथ कड़वा हो जाता है, और पुराने नमूनों में कीड़े लग सकते हैं। अगर मौसम ठंडा है तो कीटों का संक्रमण होने की संभावना नहीं है। गोमफस क्लेवेटस को कुछ समय के लिए पकाने के लिए इस्तेमाल किया गया है- फ्राइज़ ने इसे अपनी पुस्तक सिवेरीज़ ( स्वीडन में एडिबल औरपॉइज़नस मशरूम ) में शामिल किया। यह मेक्सिको के ओक्साका , और शेरपा लोगों के नेपाल में इक्ष्लान डे जुआरेज़ के ज़ापोटेक लोगों द्वारा बहुत माना जाता है।
रासायनिक प्रतिक्रिया
गोमफस क्लेवेटस फलों के पिंडों से तैयार अर्क में एक उच्च एंटीऑक्सिडेंट गतिविधि होती है, और फेनोलिक और फ्लेवोनोइड यौगिकों की एक उच्च एकाग्रता होती है। कवक से पहचाने जाने वाले फेनोलिक यौगिकों में प्रोटोकोच्यूइक एसिड , गैलिक एसिड , जेंटिसिक एसिड , वैनिलिक एसिड , सीरिंजिक एसिड , सिनैमिक एसिड , कैफिक एसिड , फेरुलिक एसिड और टैनिक एसिड शामिल हैं । तुर्की के दक्षिण ईजियन क्षेत्र से संग्रह के एक रासायनिक विश्लेषण में, कवक को भोजन पर यूरोपीय संघ वैज्ञानिक समिति द्वारा सुझाए गए अधिकतम सेवन से अधिक जहरीले धातु कैडमियम को बायोकेम्युलेट किया गया था।
वैज्ञानिक विवरण:
पारिस्थितिकी:
कोनिफ़र (विशेष रूप से स्प्रिंग्स और फ़िरस) के साथ माइकोराइज़ल; उत्तरी और उत्तरी अमेरिका में अकेले, बिखरे हुए या भव्य रूप से बढ़ रहा है; गर्मियों और पश्चिम तट पर सर्दी पड़ती है। सचित्र और वर्णित संग्रह कैलिफ़ोर्निया, ओरेगन और क्यूबेक के हैं।
फ्रूटिंग बॉडी:
एक साझा तने से उत्पन्न होने वाली एक, दो, या अधिक कैप वाली परिपक्वता द्वारा और अक्सर उनके किनारों पर एक साथ फ़्यूज़िंग; 15 सेमी तक ऊँचा और 20 सेमी ऊपर।
टोपी:
रूपरेखा में लोबेड और अनियमित; मोटे तौर पर पहले से ही उत्तल, गहराई से उदास होकर उथला; सूखी; गंजा या कुछ बिखरे हुए, छोटे तराजू के साथ; ताजा, मलाईदार तन के लिए लुप्त होती जब बकाइन रंगों के साथ पीला भूरा।
अंडरसर्फेस:
नीचे स्टेम को चलाना; गहरी झुर्रीदार और क्रॉस-वेटेड; युवा जब आमतौर पर गहरे बकाइन या बैंगनी, लेकिन बकाइन को लुप्त होती है।
स्टेम:
अक्सर परिशुद्धता के साथ परिभाषित करना मुश्किल होता है, लेकिन आमतौर पर लगभग 2-4 सेमी ऊँचा और 1–3 सेमी चौड़ा होता है; नीचे की सफेदी; अंडरसीरफेस के पास बकाइन; कभी-कभी लाल भूरे रंग की चोट; ऊपर गंजा, लेकिन थोड़े मखमली आधार के साथ; बेसल मायसेलियम सफेद।
मांस:
पीला सफेद पीला बकाइन।
गंध और स्वाद :
विशिष्ट नहीं।
बीजाणु प्रिंट :
ब्राउनिश।
सूक्ष्म विशेषताएं :
बीजाणु 11–16 x 4.5–6.5 माइक्रोन; लम्बी दीर्घवृत्ताकार से सबम्यग्दलफॉर्म तक; अक्सर अवास्तविक पक्ष पर चपटा होता है; verrucose; कई तेल की बूंदों के साथ, KOH में भूरा हो सकता है। क्लैंप कनेक्शन मौजूद।